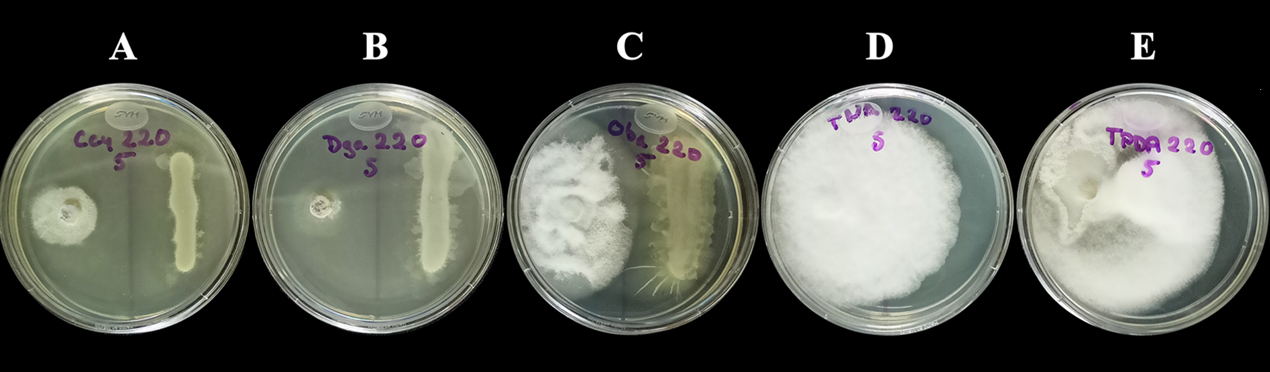

Arboles exóticos invadiendo el bosque
Guadalupe Williams-Linera1 y Milton H. Díaz-Toribio2

Las especies exóticas pueden ser invasoras, muchas son herbáceas, pero hay árboles que pueden estar invadiendo bosques no perturbados.
Guadalupe Williams-Linera1 y Milton H. Díaz-Toribio2

Las especies exóticas pueden ser invasoras, muchas son herbáceas, pero hay árboles que pueden estar invadiendo bosques no perturbados.
Rodrigo Lasa y Antonio Guillén

El senderismo es una práctica deportiva sencilla, no competitiva, que aprovecha el propio recurso natural y que genera importantes beneficios en las comunidades rurales, el medio ambiente y la sociedad.
Eric Edmundo Hernández Domínguez1,2

Todos hemos estado en la cocina de nuestra casa buscando en algún momento el colador para tratar de quitar pedacitos de servilleta o algunas basurillas que le ha caído a nuestra bebida favorita o para retirar el bagazo de nuestro jugo. Este proceso tan cotidiano podemos decir que es la base de muchas técnicas de laboratorio usadas por los científicos para realizar sus investigaciones.
Alberto Rísquez Valdepeña

Conocida también como camarón de salmuera, el ciclo de vida de la Artemia salina es sin duda uno de los más interesantes conocidos, como si se tratase de una película de ciencia ficción.
Rogelio Macías

Ninguna especie antes ha tenido la capacidad de la nuestra para competir por recursos, esta “victoria ecológica” puede tener consecuencias que no esperábamos.
Laura Alejandra Barradas Sánchez, Alexandro Medina Chena y Rafael Villegas Patraca
USPAE

Siguiendo por la carretera, sintiendo el aroma a salitre cada vez más intenso al avanzar, con el presagio de pronto vislumbrar al mar fundirse con el cielo al horizonte y escuchar el rugir de las olas al romper sobre la arena.
Eva López Tello Mera
Red de biología y conservación de vertebrados

El gato montés (Lynx rufus) es una de las seis especies de felinos que habitan en México, es de tamaño mediano y el tercer felino más grande en el país después del jaguar (Panthera onca) y el puma (Puma concolor). Se alimenta principalmente de pequeños mamíferos y es más activo durante el crepúsculo y la noche.
Nohemí Carreras Villaseñor y Diana Sánchez Rangel

Las plantas también sienten el frío, eso es un hecho, pero el cómo es una incógnita que los científicos aún no han resuelto del todo.
Dra. Lilit Pogosyan1, Dr. Alejandro Terrazas Mata2, Dra. María Guadalupe Méndez Cárdenas3, Sandra López Balderas4, Anaid Salazar Rodríguez5, Cayetano Ebana Ebana Alene6

Después de 10 años de investigación en África, presentamos nuestras reflexiones sobre nuestra experiencia de llevar a cabo un proyecto tan lejos de la casa.
Valeria Huerta Saavedra1, Armando Contreras-Hernández1 y Carolina Álvarez-Peredo1

Los bosques de México poseen una gran importancia debido al papel biológico que desempeñan y a sus funciones socioecológicas. Actualmente, y a partir del auge del concepto de sustentabilidad en los años 80´s, el diseño de estrategias de aprovechamiento forestal se debate en la disyuntiva entre maximizar la producción o fomentar la conservación de los recursos forestales.
Janet Nolasco Soto, Jorge González Astorga y Alejandro Espinosa de los Monteros
Red de Biología Evolutiva

Las cícadas surgieron durante el período Pérmico. En el mundo existen 375 especies, siendo México el segundo país con mayor diversidad de especies, entre ellas una de las más interesantes es Zamia paucijuga.
Moctezuma-Pérez Itzel, Domínguez-Gutiérrez Mario, Jiménez-Fuentes Víctor, Martínez-Landa Edgar, Ortega Sánchez Carlos, Gaitán-Hernández Rigoberto*

Los biofertilizantes son alternativas sostenibles de fertilización vegetal, aportan materia orgánica y carbono al suelo, disminuyen las emisiones de GEIs, y los efectos negativos de los fertilizantes sintéticos en el ambiente.
Juan José Barrios-Gutiérrez1, Miguel Calixto Rojas2, Natalia Tepox Vivar1 y Carlos Daniel Pinacho-Pinacho3

Los organismos encuentran formas para adaptarse a vivir hasta en las condiciones más difíciles o extrañas; esto aplica incluso para los ectoparásitos de peces.
Alberto González Gallina, Rafael Villegas Patraca y Griselda Benítez Badillo

La infraestructura verde resulta una solución clave para abordar los retos climáticos en las ciudades.
Carmen Maganda Ramírez1 y Laura Ocampo Menez2

Presentamos aquí una reflexión de las ciencias cognitivas, y en particular de la psicología ambiental como una disciplina de apoyo para el estudio de la relación sociedad-naturaleza, y de los programas de conservación.
Maite Lascurain1, Estefania Avila2, Israel Acosta3 y Helio M. García4

El chagalapoli o capulín de mayo (Ardisia compressa) es un arbolito silvestre con frutos comestibles de color morado oscuro de sabor agridulce.
María Teresa Mejía Saulés

México tiene 64 especies de bambúes nativos, incluyendo 43 especies endémicas. El 60% de estas especies forman parte de la colección nacional de bambúes nativos, albergada en el jardín botánico “Francisco Javier Clavijero” del INECOL.
Estrella Chévez* y Luciana Porter Bolland**

Hablamos de la importancia de los paisajes diversos y libres de contaminantes para la producción de miel, beneficiando a abejas sin aguijón en Veracruz.
Yessica Rico, Efraín Noriega Rico y Luis Rey Flores
Red de Diversidad Biológica del Occidente Mexicano

Las plantas en humedales son cruciales para la vida acuática. Ante su acelerada pérdida, conocer cómo ocurren los procesos de dispersión y flujo de genes entre humedales ayudará a informar estrategias de conservación.
Arantxa P. Huerta-Arvizu*, Sergio Albino** y Carolina Valdespino**

La zorra gris (Urocyon cinereoargenteus) es un cánido cosmopolita que podemos encontrar en el Santuario de Bosque de Niebla en Xalapa, Veracruz. Al ser cánido marca con orina y excretas los caminos que recorre para dar aviso del espacio que ocupa a otros organismos.
Alfonso Díaz Rojas1 e Ivette Chamorro Florescano2

México es uno de los países reconocido por la gran diversidad de plantas y animales que presenta a nivel mundial. Entre ellos, está la diversidad de peces que comprende un total de 2763 especies y que representan el 9.8% a nivel mundial. De los cuales, son conocidas 505 especies de peces dulceacuícolas, 145 de ellas son especies primarias; es decir, que son dulceacuícolas obligadas.
César Augusto Gallo Gómez, Oswaldo Trinidad Hernández, Rodolfo Augusto López Polanco y Rafael Villegas Patraca

Es de vital importancia que los proyectos de desarrollo cuenten con una delimitación de un sistema ambiental, que provea un contexto del sitio donde serán ubicados los proyectos con respecto a las características ambientales de su alrededor.
Didier Casanova Hernández1, Carlos Daniel Pinacho Pinacho2, Miguel Calixto Rojas2, Ernesto Velázquez Velázquez3, Jesús Alejandro Zamora Briseño2

Los parásitos son organismos que viven sobre o en el interior de otros, causándoles problemas en su estado de salud. Mientras tanto, al organismo que alberga al parásito se le conoce como hospedero. Dicho de otra forma, los parásitos viven a merced de su hospedero, quien lo resguarda y le brinda los recursos necesarios para sobrevivir. Para el hospedero, la presencia del parásito frecuentemente le resulta problemática, puesto que le puede provocar problemas de salud o incluso la muerte.
Lucas A. Fadda, Luis Osorio-Olvera &Andrés Lira-Noriega

Las invasiones biológicas amenazan la biodiversidad en México. Simulaciones computacionales ayudan a elaborar estrategias de manejo para mitigar sus daños y proteger ecosistemas naturales y cultivados.
Méndez Barredo Liliana Hortencia1*, Monribot Villanueva Juan Luis2, Guerrero Analco José Antonio2, Ruiz May Eliel1*

La etnobotánica preserva conocimientos tradicionales sobre el uso de plantas incluyendo sus propiedades medicinales, muchas veces transmitidos por mujeres indígenas. El Día Internacional de los Pueblos Indígenas celebra los derechos, cultura y contribuciones únicas de nuestros pueblos originarios.
Marie-Stéphanie Samain
Red de Diversidad Biológica del Occidente Mexicano

El periodismo ambiental evidencia las fuerzas y actores que tienen un efecto negativo sobre los ecosistemas, así como las acciones que se están realizando para contrarrestar esa situación.
Ana Laura Lara-Domínguez, Jorge López-Portillo, Arturo Zaldívar Jiménez y Rosela Pérez Ceballos

El Golfo de México (GdM), con una superficie de 1.55 millones de km2 es el segundo del mundo después del Golfo de Bengala. Está rodeado por tres países (Estados Unidos, México y Cuba) y en él desembocan grandes sistemas fluviales, como la cuenca del río Misisipi (3.2 millones de km2), y los ríos más caudalosos de México.
Ulises Antonio Ponce Pretelin1 y Yoshajandith Aguirre Vidal2

La ergonomía y la salud ocupacional son esenciales para entornos laborales saludables, ayudan a prevenir lesiones y fomentan la productividad mediante adaptaciones y bienestar integrado.
Emanuel Villafán de la Torre

En las últimas décadas, el avance de las tecnologías de secuenciación de nueva generación ha permitido la obtención de grandes volúmenes de datos genéticos, transformando así los estudios genómicos que antes se limitaban a unos pocos genes o regiones específicas del ADN. Este cambio ha impulsado la necesidad de nuevos métodos de análisis, donde el aprendizaje computacional o machine learning ha desempeñado un papel crucial.
Victor M. Bandala, Elena Vera, Leticia Montoya, David Ramos
Red Biodiversidad y Sistemática

Liquen: producto de una simbiosis entre una o más especies de hongos interactuando con organismos fotosintéticos, es suma exitosa de esfuerzos en la naturaleza.
Arith Pérez-Orozco y Victoria Sosa

Los antioxidantes vegetales protegen las células contra los radicales libres ya que poseen antioxidantes, ayudando a combatir el estrés oxidativo, favoreciendo la salud.
Citlalli Alhelí González Hernández
El equipo de científicos de Geo-Sports.org nos invita a explorar las maravillas naturales de los paisajes en la ruta ciclista del Tour de Francia.
Sonia Galicia1, Víctor Luna-Monterrojo2 y Andrew P. Vovides1

Las cícadas y el ginkgo son las únicas plantas con semillas que tienen gametos masculinos flagelados, que les permiten desplazarse para alcanzar el óvulo.
Karla L. Tapia-Fierro, Nimitz Y. Vázquez -Rubio, Juan Carlos Serio-Silva

Las tesis son una contribución científica relevante que no trasciende por su limitada disponibilidad y en el INECOL surge Prima-T, una biblioteca virtual de tesis de primates accesible al público.

Los equinodermos son animales marinos bentónicos; sobreviven 7,000 especies. Sus larvas mantienen la simetría bilateral pero sus adultos presentan una simetría radial (pentarradiada) en algunos casos, superpuesta, una simetría bilateral secundaria. Tienen un endoesqueleto calcáreo de origen mesodérmico y púas. Son de vital importancia en la cadena alimenticia, en el equilibrio ecológico y como productores de oxígeno.
Sergio Albino1 y Cesar D. Jiménez-Piedragil2

A lo largo de millones de años, la vida en nuestro planeta ha evolucionado y diversificado de formas inimaginables.
Carolina Camacho Vázqueza*, Juan Luis Monribot Villanuevaa, Martín Alujab y José Antonio Guerrero Analcoa*

Las manzanas son una fuente importante de compuestos fenólicos sanos debido a su disponibilidad durante todo el año y a su consumo habitual en la dieta humana.
Sandra Rocha Ortiz, Angelina Ruiz Sánchez, Emilio A. Suárez Domínguez, Ibiza Martínez Serrano, Julliana Barretto, Pascual Linares Márquez, Rodolfo Martínez Mota y Eliezer Cocoletzi Vásquez

El matorral xerófilo que se presenta en el malpaís de Perote, alberga especies endémicas y ofrece importantes servicios ecológicos.


Es bien sabido que, los autos que funcionan con combustibles fósiles lanzan al ambiente gases sumamente tóxicos. Los benzopirenos son producidos por motores Diesel y provocan cáncer en la población. El óxido nitroso y las partículas de CO2 provienen de los vehículos a gasolina, son sumamente tóxicos también, son responsables de la fibrosis pulmonar y cáncer.
Andrew P. Vovides
Red de Biología Evolutiva

Durante tiempos pre-Hispánicos los jardines botánicos existían en México, pero se hallaban a punto de exterminio durante la conquista. Fue hasta la época moderna que se establecieron de nuevo; en Tuxtla Gutiérrez, Chiapas, y del Instituto de Biología, UNAM en los años 1930s y 1950s respectivamente.
Rodolfo Novelo-Gutiérrez y Daniel Reynoso-Velasco
Red de Biodiversidad y Sistemática

Los plecópteros son insectos acuáticos con una vida adulta terrestre. Los huevos y las formas juveniles se desarrollan en cuerpos de agua dulce, principalmente arroyos y ríos. Se conocen actualmente alrededor de 4,000 especies agrupadas en 16 familias a nivel mundial.
Carlos Alberto Rebolloso Hernández 1 , Moisés Roberto Vallejo Pérez 2 y Cuauhtémoc Deloya 3

El mercurio es un metal que recientemente se identificó como una amenaza para la entomofauna y en México existen sitios contaminados que representan riesgos para estos seres vivos.
Roberto Arce-Pérez y Emmanuel Arriaga-Varela

Entre los escarabajos menos conocidos por su diminuto tamaño (0.4 mm a 2 mm) están los del suborden Myxophaga, ahora infórmanos de su presencia y distribución en México.
Fernando González García
Red de Biología y Conservación de Vertebrados

En estos tiempos de sequía y cambio climático, la fauna silvestre se enfrenta a una gran dificultad para encontrar agua.
Nicolaza Pariona Mendoza1, Leonel López Sandoval2, Ana Leydi Gonzáles Coutiño2, Deyma Marisol Mejía Hernández2, Juan Carlos Herrera Sánchez2, Luis Arturo Ibarra Juárez1,3

Como parte del proceso de cría de insectos se producen excretas (debris), que contienen minerales que pueden ser utilizados como biofertilizantes.
Eurídice Tinoco-Domínguez, Guadalupe Amancio, Andrés Lira-Noriega

Los muérdagos americanos, que pertenecen al género Phoradendron, son recursos importantes en los ecosistemas ya que establecen interacciones cercanas con hospederos, dispersores y polinizadores.
Rosa María Arias Mota, Yadeneyro de la Cruz Elizondo y Laura Celina Ruelas Monjardín

Los HMA son aliados valiosos en la agricultura sostenible y su uso en la producción de café puede ser una pieza clave para incursionar en la producción de café orgánico.
Ximena A. Galindo-Malagón1,2 y Daniel Reynoso-Velasco1

Las chinches son un interesante grupo de insectos que tienen una gran diversidad de formas y colores, es posible encontrarlas en una variada gama de ambientes como terrestres, acuáticos y semiacuáticos. Para la colonización de estos ambientes las chinches han tenido cambios en la forma y función de su cuerpo.
Tlacaelel Rivera-Núñez1, Alberto López Arcadia2, Andres Contreras-Mora3, Brenda Ratoni3, Edgar Uriel Echavarría Domínguez3, Ixtoc Marlo Rivera-Núñez4, Milton Javier Rubiano Guzmán3, Sofía Lail Lugo-Castilla2, Ernesto Ruelas Inzunza5, Fabricio Villalobos6, Javier Laborde7, Juan E. Martínez-Gómez8, Juliana Merçon9, Karina Boege10, Wesley Dáttilo11

Históricamente, la actividad científica ha estado marcada por un legado colonial que ha forjado su desarrollo. Desde los inicios de las colonias europeas y su expansión moderna, el conocimiento científico ha sido empleado para legitimar y perpetuar los sistemas de dominación y explotación (1).
Nidia Sánchez León1,2 y Eric Hernández Domínguez1,3

Las plantas al igual que los humanos responden a los ciclos de luz y obscuridad, de transmiten impulsos eléctricos, además, sorprendentemente también emiten sonidos.
Guillermo López Escalera Argueta
Oficina de comunicación

En el vasto universo de las ideas, la creatividad ha sido comparada con procesos naturales y científicos, ofreciendo un lente único para explorarla y comprenderla.
M. Luisa Martínez
Red de Ecología Funcional

Todos los seres vivos tienen condiciones de temperatura en las que sobreviven y crecen mejor. En condiciones extremas requieren respuestas especiales para no morir.
Carol Alexis Olivares García, Martín Mata Rosas y Eliel Ruíz May

El desarrollo y la aplicación de las ciencias ómicas en años recientes al cultivo in vitro ha permitido mejorar enormemente la investigación en biología vegetal.
Luis M García Feria

La importancia de la conservación de la biodiversidad ha llevado a desarrollar estrategias para su conservación a corto, mediano y largo plazo.
Carlos I. Flores Romero y Rosa María González Amaro
Red Ambiente y Sustentabilidad

El maíz es el alimento más importante en la República Mexicana, por lo que es necesario optimizar su producción y conservación de manera inocua.
Alberto R. Jácome Hernández y Damaris Desgarennes
Red de Biodiversidad y Sistemática
Los microbiomas o comunidades microbianas de plantas son una fuente importante de microorganismos que puedan ser implementados para el manejo de fitopatógenos.
Itzel Moctezuma Pérez1,2, Mario Domínguez Gutiérrez1, Rigoberto Gaitán Hernández1 y Claudia Anahí Pérez Torres2,3

La formación de suelos tarda miles de años, desgastarlos sólo unos cuantos, una alternativa para restaurarlos es la aplicación de vermicomposta que aporta nutrientes, materia orgánica, carbono, microorganismos, ácidos húmicos, y ayuda a recuperar su estructura física.
Enlaces institucionales y comité organizador del LNC-MexFlux*

MexFlux es un nuevo Laboratorio Nacional Conahcyt y lidera la investigación de las interacciones entre los ecosistemas y la atmósfera al monitorear el intercambio de agua, energía, y gases de efecto invernadero, promoviendo soluciones climáticas naturales.
Patricia Romero-Arellano y Edgar Guevara-Avendaño*

Los microbios producen un arsenal de compuestos químicos aéreos que afectan a los microorganismos patógenos. Estos compuestos volátiles pueden ser aprovechados para desarrollar biopesticidas.
Enrique Ibarra-Laclette1, Eva García-Ilizaliturri1, Antonio Cárdenas-Flores2, Carlos Espinoza-González3, Claudia Anahí Pérez-Torres1,4

¿Sabías que muchos de los genes codificados en el genoma de todo organismo responden a distintos estímulos incluida la deficiencia de nutrientes?